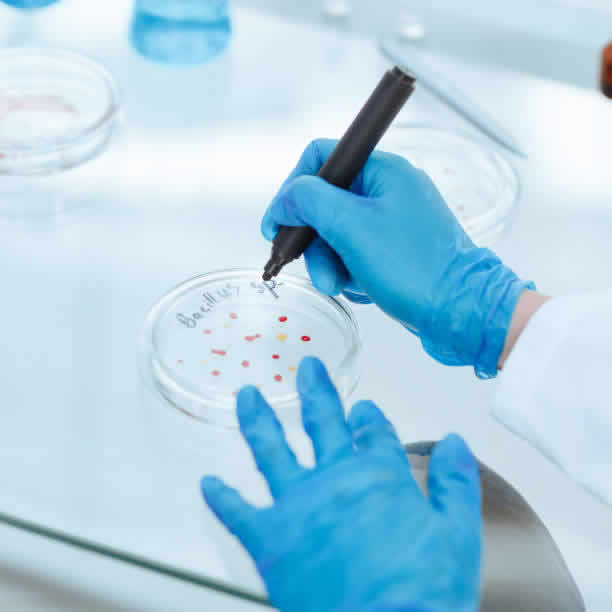

2026年揚(yáng)州試管嬰兒的費(fèi)用大致在3萬元到8萬元人民幣之間。具體費(fèi)用會根據(jù)使用的技術(shù)、藥物種類、促排方案以及患者的身體狀況而有所不同。初步檢查費(fèi)用大約在3000...
發(fā)布時(shí)間:2025-12-22 06:25 瀏覽次數(shù):110

以下是對揚(yáng)州地區(qū)三代試管嬰兒醫(yī)院的盤點(diǎn),其中江蘇省民眾醫(yī)院生殖醫(yī)院、南京尚故醫(yī)院生殖醫(yī)院、南京市生育保健院生殖醫(yī)院、徐州醫(yī)科大學(xué)所屬醫(yī)院生殖醫(yī)院、東南大學(xué)所屬中...
發(fā)布時(shí)間:2025-12-20 23:36 瀏覽次數(shù):287

揚(yáng)州試管嬰兒服務(wù)哪家強(qiáng)?一家揭秘?fù)P州私人試管機(jī)構(gòu)排名近年來試管嬰兒技術(shù)成為越來越多不孕不育夫妻的福音。揚(yáng)州,這座江蘇省的重要城市,也涌現(xiàn)出多家提供試管嬰兒服務(wù)的...
發(fā)布時(shí)間:2025-12-20 09:15 瀏覽次數(shù):233

探討試管嬰兒技術(shù)時(shí),一個(gè)常見問題是未婚個(gè)體是否能夠利用這種技術(shù)。在多數(shù)和地區(qū)試管嬰兒技術(shù)主要用于幫助那些因生理原因無法自然受孕的已婚夫婦實(shí)現(xiàn)生育愿望。然而隨著社...
發(fā)布時(shí)間:2025-12-20 02:56 瀏覽次數(shù):73

在生育的道路上,部分家庭可能會遇到一些困難,而輔助生殖技術(shù),特別是第三代試管嬰兒(IVF)技術(shù),為他們帶來了新的希望。揚(yáng)州作為一座歷史文化名城,其醫(yī)療水平也在不...
發(fā)布時(shí)間:2025-12-18 20:09 瀏覽次數(shù):161
以下將為您帶來2026年揚(yáng)州試管嬰兒醫(yī)院排名及相關(guān)信息介紹,希望能幫助您找到理想的生育醫(yī)院。為了讓您更好地了解不同醫(yī)院的特點(diǎn),我們將根據(jù)醫(yī)院成功率、費(fèi)用以及專業(yè)...
發(fā)布時(shí)間:2025-12-17 19:54 瀏覽次數(shù):249

2026年在揚(yáng)州做試管嬰兒助孕大概需要多少錢?預(yù)計(jì)總費(fèi)用在3萬到8萬元人民幣之間。2026年揚(yáng)州試管嬰兒總費(fèi)用預(yù)估2026年在揚(yáng)州進(jìn)行一次完整的試管嬰兒周期,總...
發(fā)布時(shí)間:2025-12-17 18:25 瀏覽次數(shù):194

試管嬰兒技術(shù)是一項(xiàng)偉大的醫(yī)學(xué)進(jìn)步,為那些渴望成為父母但面臨生育困難的夫婦提供了新的希望。然而試管嬰兒治療的法規(guī)和條件一直備受爭議,其中一個(gè)備受關(guān)注的問題是是否需...
發(fā)布時(shí)間:2025-12-15 00:42 瀏覽次數(shù):92

選擇做三代試管的原因很多,可能是遺傳疾病家族史,也可能是夫妻雙方自身的身體狀況導(dǎo)致生育困難。無論哪種原因,在決定進(jìn)行三代試管之前,需要仔細(xì)了解整個(gè)流程以及相關(guān)費(fèi)...
發(fā)布時(shí)間:2025-12-13 17:36 瀏覽次數(shù):62

在揚(yáng)州以揚(yáng)州大學(xué)附屬醫(yī)院為例,做三代試管嬰兒的費(fèi)用大約在5-8萬元之間。這只是一個(gè)大致的范圍,具體費(fèi)用會根據(jù)患者的個(gè)體情況、治療方案以及選擇的項(xiàng)目有所差異,例如...
發(fā)布時(shí)間:2025-12-12 22:12 瀏覽次數(shù):79





兩個(gè)女生去哈薩克斯坦做試管嬰兒花20全能搞定嗎?
根據(jù)您提供的信息,20萬元人民幣在哈薩克斯坦進(jìn)行試管嬰兒治療是可能實(shí)現(xiàn)的,但具體能否完全覆蓋所有費(fèi)用,還需要...
國外試管成功歸來,單身女性如何為寶寶上中國戶口?
單身女性在國外通過試管嬰兒技術(shù)生育的寶寶,回國辦理戶口需要遵循我國的戶籍管理規(guī)定。由于您是單身狀態(tài),且寶寶是...
泰國EK試管醫(yī)院正規(guī)嗎技術(shù)怎么樣?費(fèi)用大概多少?
泰國EK試管醫(yī)院是泰國一家有名氣的輔助生殖醫(yī)院,其正規(guī)性、技術(shù)水平和費(fèi)用是許多考慮前往泰國進(jìn)行試管嬰兒的家庭...
在柬埔寨單身女生能做試管嬰兒嗎?
柬埔寨對于單身女性進(jìn)行試管嬰兒治療的態(tài)度相對開放,法律上并未明確禁止單身女性進(jìn)行輔助生殖技術(shù)。然而,實(shí)際操作...

電話:156 2333 9999
地址:泰國曼谷中央商務(wù)區(qū)帝國大廈

電話:400-1518-900
地址:曼谷市中心拉瑪三區(qū)73巷

電話:400-1518-900
地址:1126/2 Vanit Building II, Lobby Floor, New Petchburi Road, Makkasan, Ratchathewi, Bangkok 10400

電話:400-1518-900
地址:90,Sriracha Nakorn 3rd Chonburi,Si Racha,春武里20110 TH

電話:400-1518-900
地址:2483 New Phetchaburi Rd, Khwaeng Bang Kapi, Khet Huai Khwang Bangkok

電話:400-1518-900
地址:5 Soi Chidlom, Ploenchit Road, Lumpinee, Pathumwan, Bangkok 10300